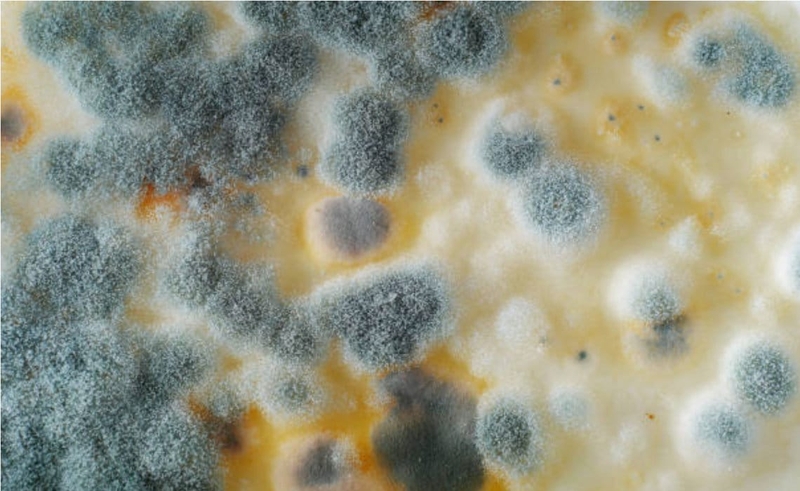
Biểu hiện bệnh lang ben là gì 1

Dược sĩ chuyên ngành Dược lâm sàng, với nhiều năm kinh nghiệm làm việc trong lĩnh vực dược phẩm. Là Dược sĩ Long Châu đạt được chứng chỉ bệnh học cấp quốc tế. Hiện đang là giảng viên tại Trung tâm Đào tạo FPT Long Châu.
Biểu hiện bệnh lang ben là gì?
21/06/2023
Mặc định
Lớn hơn
Nấm Pityrosporum ovale phát triển rầm rộ trên da sẽ biểu hiện bệnh lang ben. Bệnh lang ben không gây nguy hiểm tới tính mạng nhưng gây mất thẩm mỹ và nhiều bất tiện trong sinh hoạt hàng ngày. Tuy nhiên, với phương pháp điều trị và chăm sóc đúng cách, bệnh lang ben hoàn toàn có thể bị loại bỏ.
Dấu hiệu điển hình và đầu tiên biểu hiện bệnh lang ben là hiện tượng xuất hiện vùng da bị đổi màu hồng, trắng hoặc nâu với bề mặt là vảy cám mịn, dễ cạo. Vùng da bị tổn thương ít khi ngứa hay đau rát. Bệnh dễ dàng lây truyền bằng đường tiếp xúc da, sử dụng chung đồ dùng sinh hoạt cá nhân. Ngoài ra, bệnh dễ tái phát nếu không điều trị dứt điểm hay chăm sóc làn da đúng cách.
Bệnh lang ben là gì?
Bệnh lang ben với tên khoa học là Pityriasis versicolor là một bệnh da liễu thường gặp, gây ra bởi nấm men Pityrosporum ovale (tên khác là Malassezia furfur) sống hoại sinh trên da người. Ngoài bệnh lang ben, loại nấm này còn có thể gây viêm nang lông (Pityriasis folliculitis), viêm da tăng tiết bã (seborrhoeic dermatitis), gầu (dandruff), đôi khi xâm nhập máu gây nhiễm nấm máu.
Trong thời kỳ bùng phát, biểu hiện bệnh lang ben thường gặp là da đổi màu trắng, hồng hay nâu, ngứa ngáy, rát nóng, khó chịu…Và nhiễm bệnh chủ yếu ở nửa người trên như mặt, cổ, lưng. Bệnh lang ben không ảnh hưởng trực tiếp tới sức khỏe người bệnh nhưng lại gây nhiều bất tiện tới sinh hoạt hàng ngày cũng như gây mất thẩm mỹ ở vùng da bị bệnh. Đồng thời, bệnh lang ben tuy có thể chữa khỏi dễ dàng bởi các loại thuốc kháng nấm bôi ngoài da nhưng dễ bị tái phát.
Nấm Pityrosporum ovale là nguyên nhân gây bệnh lang ben cùng nhiều bệnh khác
Nấm Pityrosporum ovale là nguyên nhân gây bệnh lang ben cùng nhiều bệnh khácNguyên nhân và yếu tố nguy cơ bệnh lang ben
Nguồn gốc gây bệnh lang ben do sự phát triển tràn lan của nấm Pityrosporum ovale trên da người bệnh. Loại nấm này sẽ tác động đầu tiên vào lớp biểu bì của da, khiến sắc tố da bị rối loạn, dẫn tới màu da bị thay đổi.
Một số yếu tố góp phần tiến triển bệnh:
- Khí hậu nhiệt đới với thời tiết nóng ẩm.
- Da tiết nhiều dầu, đổ nhiều mồ hôi gây bít tắc lỗ chân lông, đồng thời tạo môi trường cho nấm phát triển.
- Bệnh nhân suy giảm miễn dịch như bệnh nhân nhiễm HIV/AIDS, bệnh tiểu đường, ung thư…
- Người sử dụng thuốc prednisone ức chế miễn dịch, điều trị ung thư bằng hóa chất, điều trị kháng sinh phổ rộng trong thời gian dài…
- Trẻ đang ở tuổi dậy thì, phụ nữ đang trong thời kỳ mang thai khiến nội tiết tố thay đổi.
- Vệ sinh cá nhân chưa sạch sẽ.
 Vệ sinh thân thể không sạch góp phần gây bệnh lang ben
Vệ sinh thân thể không sạch góp phần gây bệnh lang benBiểu hiện bệnh lang ben
Lang ben thường lây lan chủ yếu ở nửa người trên, đặc biệt những vùng dễ đổ mồ hôi như cổ, tay, mặt hay lưng. Biểu hiện khởi phát là vùng da nhiễm bệnh sẽ giảm hoặc mất sắc tố làm màu da trắng hơn vùng da xung quanh.
Đồng thời, rối loạn sắc tố da khiến vùng da bị nhiễm nấm không được bảo vệ khỏi tia cực tím, nên càng ra nắng thì vùng da bị bệnh càng sẫm màu khiến nơi tổn thương càng hiện rõ.
Khi bệnh tiến triển nặng hơn, vùng da bị nhiễm nấm sẽ xuất hiện những mảng da điển hình với những tính chất sau đây:
- Màu sắc: Da thường chuyển màu trắng, hồng hoặc nâu.
- Kích thước: Đám tổn thương thường có đường kính từ 1 tới 3cm.
- Hình dạng: Hình bầu dục, hình tròn hay hình đa cung.
- Bề mặt có vảy cám mịn, có thể sử dụng dụng cụ cạo bong dễ dàng, gọi là dấu hiệu vỏ bào.
- Biểu hiện: Vùng da tổn thương không đau, ít ngứa.
- Khi chiếu dưới ánh đèn wood, vùng da bị lang ben sẽ phản ứng và phát ra ánh sáng huỳnh quang màu xanh lá cây.
Đặc biệt, tiết trời mùa hè khiến da đổ nhiều mồ hôi khiến cơn ngứa ngáy tăng lên, người bệnh gãi gây xước da khiến nguy cơ nhiễm trùng da tăng lên ở vùng da bị lang ben.
 Đặc trưng cho biểu hiện bệnh lang ben là vùng da đổi màu
Đặc trưng cho biểu hiện bệnh lang ben là vùng da đổi màuĐiều trị bệnh lang ben
Tuy bệnh lang ben không gây ảnh hưởng nhiều tới sức khỏe, nhưng bệnh lan rộng nhanh, dễ tái phát và gây mất thẩm mỹ.
Mẹo điều trị tại nhà
Nếu bệnh lang ben được phát hiện sớm khi bệnh còn nhẹ, bạn có thể áp dụng một số mẹo dân gian giúp làm dịu tình trạng bệnh với các nguyên liệu dễ dàng tìm kiếm:
- Rau răm: Sử dụng một nắm rau răm, rửa sạch và ngâm nước muối khoảng 15 phút. Sau đó, giã nát rau răm để chắt lấy nước cốt, sử dụng bông gòn bôi nhẹ nhàng lên vùng da nhiễm lang ben. Để khô tự nhiên, không cần rửa lại.
- Riềng: Sử dụng một củ riềng nhỏ, rửa sạch, giã nhuyễn. Sau đó, vắt thêm 3 tới 4 giọt nước cốt chanh. Trộn đều, lọc lấy nước cốt, sử dụng bông gòn và bôi nhẹ nhàng lên vùng da tổn thương. Không cần rửa lại với nước hay lau khô bằng khăn, để khô tự nhiên.
- Nhựa chuối xanh: Chọn quả chuối còn xanh và non có nhiều nhựa. Cắt chuối thành từng lát mỏng và đắp lên vùng da bị lang ben. Đắp trong vòng 1 tới 2 tiếng rồi rửa lại với nước sạch.
Điều trị với thuốc
Với thuốc bôi ngoài da, có một số loại thuốc bôi chống nấm như:
- Clotrimazole: Sử dụng 2 lần/ngày trong vòng 4 tới 8 tuần.
- Miconazole: Bôi lên vùng da bị bệnh 2 lần/ngày, thường bôi liên tục từ 2 tới 5 tuần. Sau khi tổn thương đã khỏi, cần bôi thêm 1 tuần ngừa bệnh tái phát.
- Terbinafine: Bôi kem ngoài da hoặc xịt dung dịch vào vùng da bệnh 2 lần/ngày trong 2 tuần.
- Ciclopirox: Bôi kem ngoài da hoặc lotion 0,77% 2 lần/ngày, hiệu quả của thuốc thường đạt được sau 2 tuần sử dụng.
Với thuốc uống, bác sĩ thường chỉ định thuốc sử dụng đường uống đối với trường hợp lang ben giai đoạn nặng hoặc tái phát nhiều đợt. Thuốc đường uống chỉ sử dụng trong thời gian ngắn, có thể gặp tác dụng phụ và phản ứng tương tác với thuốc khác mà bệnh nhân đang sử dụng. Một số loại thuốc phổ biến:
- Ketoconazole: Sử dụng 200mg/ngày trong vòng 5 đến 7 ngày.
- Itraconazole: Sử dụng 100 đến 200mg/ngày trong 5 ngày.
- Fluconazole: Sử dụng 300mg/tuần trong vòng 2 tuần.
 Có thể lựa chọn điều trị bệnh lang ben bằng thuốc uống hay thuốc bôi ngoài da
Có thể lựa chọn điều trị bệnh lang ben bằng thuốc uống hay thuốc bôi ngoài daChú ý, với phương pháp điều trị bệnh lang ben bằng thuốc bôi ngoài da hay thuốc uống cần có sự tư vấn kỹ càng và chỉ định từ bác sĩ. Tránh tự ý sử dụng sẽ không đạt được hiệu quả cao nhất cũng như gặp phải những tác dụng phụ không mong muốn hoặc gặp phản ứng tương tác với thuốc mà bệnh nhân đang sử dụng.
Chăm sóc trong điều trị lang ben
Trong và sau quá trình điều trị bệnh lang ben, quá trình chăm sóc vô cùng quan trọng. Chăm sóc đúng giúp đẩy lùi nhanh chóng biểu hiện bệnh lang ben, rút ngắn thời gian điều trị cũng như phòng ngừa bệnh tái phát. Một số phương pháp chăm sóc cơ thể người bệnh có thể áp dụng:
- Giữ cho làn da tổn thương luôn được khô thoáng, tránh để da tiếp xúc lâu trong môi trường nóng ẩm, môi trường có nhiệt độ quá cao.
- Tránh để da ra quá nhiều mồ hôi.
- Giữ vệ sinh cá nhân sạch sẽ.
- Giữ đồ dùng các nhân sạch sẽ, phôi khô dưới ánh nắng mặt trời hoặc sử dụng sấy khô để diệt trừ nấm.
- Không sử dụng chung đồ dùng sinh hoạt như khăn tắm, bàn chải, khăn mặt…tránh lây lan bệnh lang ben.
- Nếu điều trị, cần sử dụng thuốc bôi ngoài da và thuốc uống theo hướng dẫn và chỉ định của bác sĩ.
Trên đây là những thông tin về biểu hiện bệnh lang ben mà Nhà Thuốc Long Châu cung cấp, hy vọng qua bài viết này, độc giả có thể có những hiểu biết cơ bản về căn bệnh này. Bệnh lang ben không gây nguy hiểm tới sức khỏe người bệnh nhưng gây bất tiện trong sinh hoạt và gây mất thẩm mỹ. Ngoài ra, bệnh rất dễ lây lan và tái phát nên cần được điều trị và chăm sóc đúng cách.
Ánh Vũ
Nguồn tham khảo: Tổng hợp
Các bài viết liên quan
Top 5 kem chống nắng nâng tone trắng hồng, mịn lì được yêu thích
Những thuốc làm tăng nguy cơ da bắt nắng
5 tiêu chí chọn kem chống nắng an toàn, phù hợp cho trẻ em mà phụ huynh nên biết
Collagen, vitamin C và sắt: Vì sao nên bổ sung cùng nhau?
Ceramide là gì? Vai trò của ceramide trong mỹ phẩm
Các bước dưỡng trắng da mặt hiệu quả thường được áp dụng
DMDM Hydantoin là gì? Có vai trò gì trong mỹ phẩm?
Clean beauty là gì? Lợi ích của xu hướng clean beauty
Petrolatum là gì? Ứng dụng trong mỹ phẩm có an toàn không?
Liposome là gì? Ưu và nhược điểm của công nghệ liposome
:format(webp)/Option_1_2_2d9677e5fd.png)
:format(webp)/Option_1_1_2a84e0cd00.png)
:format(webp)/duoc_si_kim_654f239621.png)